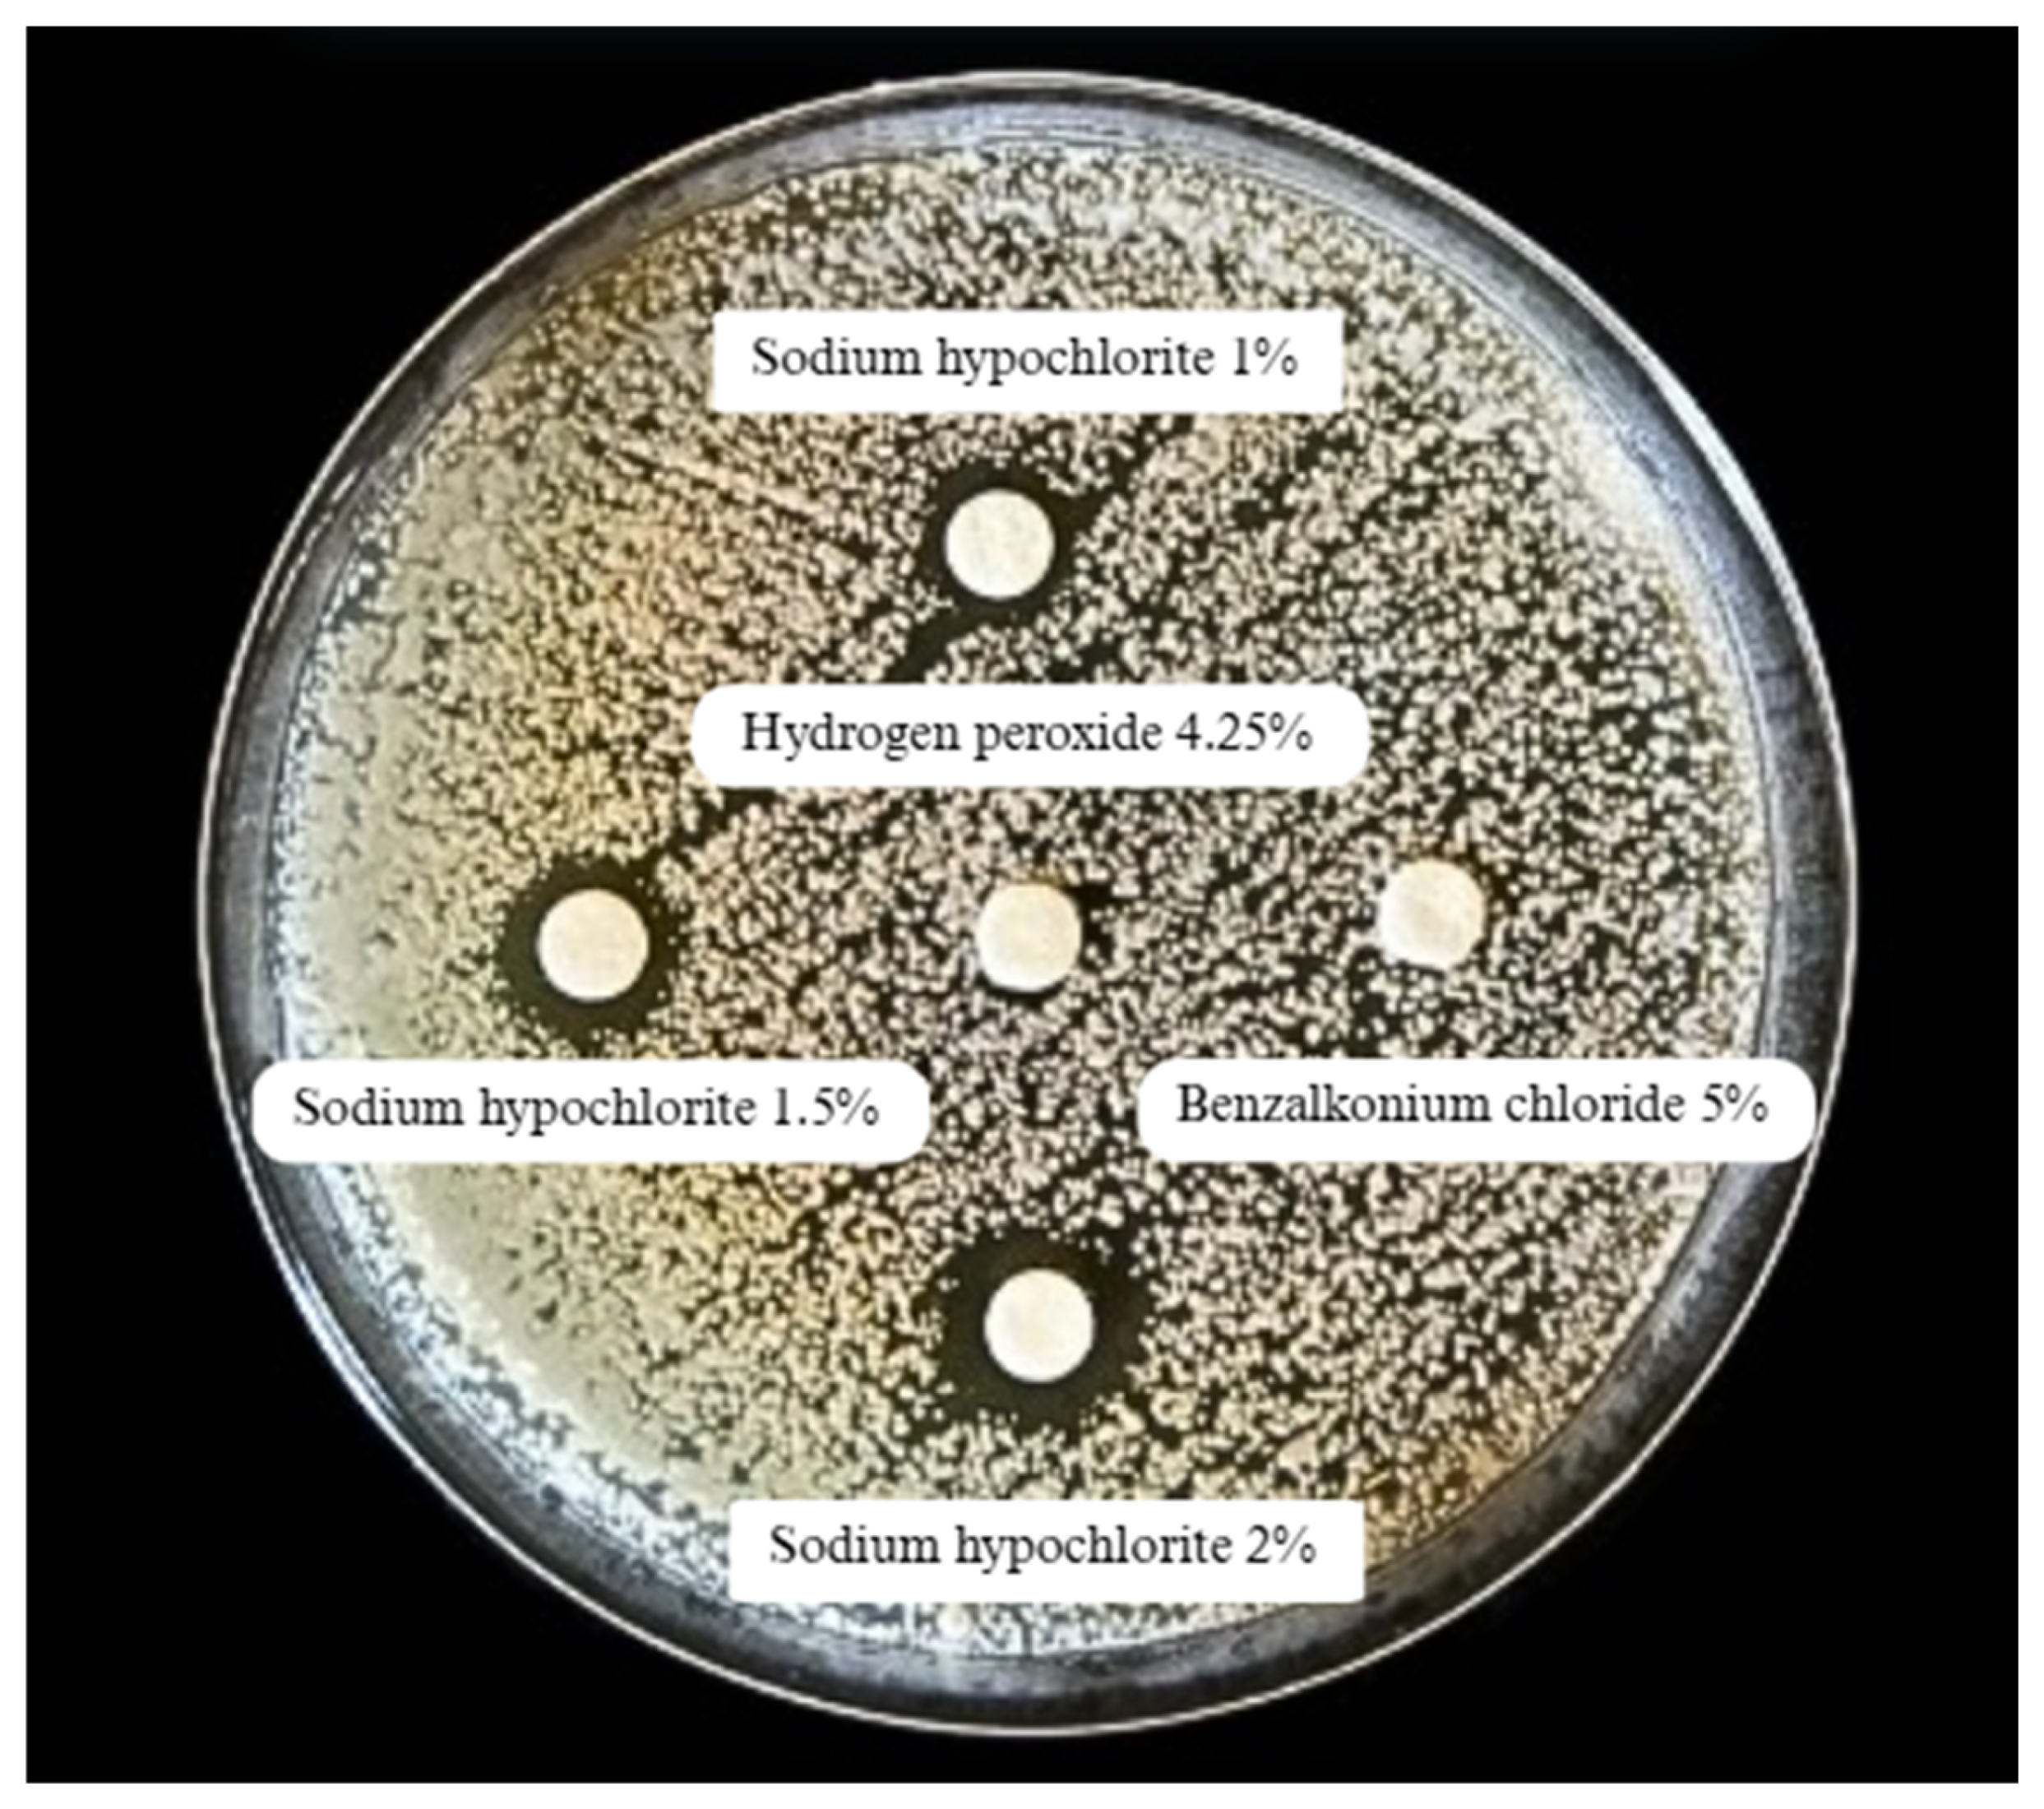
Idr 17 00097 g002

Biocide Tolerance, Biofilm Formation, and Efflux Pump Activity in Clinical Isolates of Trichosporon asahii
Abstract
1. Introduction
2. Materials and Methods
2.1. Individuals
2.2. Analysis of Medical Records
2.3. Assessment of the Integrity of Isolates
2.4. Identification of Yeasts
2.5. Assessment of Tolerance to Biocides
2.6. Evaluation of Efflux Pump Activity
2.7. Detection of Biofilm Formation
2.8. Statistical Analysis
3. Results
4. Discussion
5. Conclusions
Author Contributions
Funding
Institutional Review Board Statement
Informed Consent Statement
Data Availability Statement
Conflicts of Interest
References
- Colombo, A.L.; Padovan, A.C.B.; Chaves, G.M. Current knowledge of Trichosporon spp. and Trichosporonosis. Clin. Microbiol. Rev. 2011, 24, 682–700. [Google Scholar] [CrossRef]
- Leite, D.P., Jr.; de Oliveira, E.C.; Vasconcelos, K.R.; Vivi-Oliveira, V.K.; Oliboni, G.M.; Macioni, M.B.; de Oliveira, I.D.; Takahashi, J.P.F.; Bonfietti, L.X.; Melhem, M.d.S.C. Identification of Trichosporon yeast isolates from superficial infections in male patients from Central Brazil: An approach to the diversity of infections caused by this basidiomycete fungus. Braz. J. Biol. 2024, 84, e280451. [Google Scholar] [CrossRef]
- Liu, X.Z.; Wang, G.M.; Göker, M.; Groenewald, M.; Kachalkin, A.V.; Lumbsch, H.T.; Millanes, A.M.; Wedin, M.; Yurkov, A.M.; Boekhout, T.; et al. Towards an integrated phylogenetic classification of the Tremellomycetes. Stud. Mycol. 2015, 81, 85–147. [Google Scholar] [CrossRef] [PubMed] [PubMed Central]
- Guo, L.-N.; Yu, S.-Y.; Hsueh, P.-R.; Al-Hatmi, A.M.S.; Meis, J.F.; Hagen, F.; Xiao, M.; Wang, H.; Barresi, C.; Zhou, M.-L.; et al. Invasive Infections due to Trichosporon: Species Distribution, Genotyping, and Antifungal Susceptibilities from a Multicenter Study in China. J. Clin. Microbiol. 2019, 57, e01505-18. [Google Scholar] [CrossRef]
- Cordeiro, R.d.A.; Aguiar, A.L.R.; da Silva, B.N.; Pereira, L.M.G.; Portela, F.V.M.; de Camargo, Z.P.; de Lima-Neto, R.G.; Castelo-Branco, D.d.S.C.M.; Rocha, M.F.G.; Sidrim, J.J.C. Trichosporon asahii and Trichosporon inkin Biofilms Produce Antifungal-Tolerant Persister Cells. Front. Cell. Infect. Microbiol. 2021, 11, 645812. [Google Scholar] [CrossRef]
- de Almeida, J.N., Jr.; Hennequin, C. Invasive Trichosporon Infection: A Systematic Review on a Re-emerging Fungal Pathogen. Front. Microbiol. 2016, 7, 1629. [Google Scholar] [CrossRef]
- Bekele, T.G.; Melaku, B.; Demisse, L.B.; Abza, L.F.; Assen, A.S. Outcomes and factors associated with prolonged stays among patients admitted to adult intensive care unit in a resource-limited setting: A multicenter chart review. Sci. Rep. 2024, 14, 13960. [Google Scholar] [CrossRef]
- Lee, E.H.; Choi, M.H.; Lee, K.H.; Song, Y.G.; Han, S.H. Differences of clinical characteristics and outcome in proven invasive Trichosporon infections caused by asahii and non-asahii species. Mycoses 2023, 66, 992–1002. [Google Scholar] [CrossRef]
- Kollef, M.H.; Torres, A.; Shorr, A.F.M.; Martin-Loeches, I.; Micek, S.T. Nosocomial Infection. Crit. Care Med. 2021, 49, 169–187. [Google Scholar] [CrossRef]
- Chander, J. Textbook of Medical Mycology; JP Medical Ltd.: New Delhi, India, 2017. [Google Scholar]
- Piecuch, A.; Cal, M.; Ogórek, R. Adhesion and biofilm formation by two clinical isolates of Trichosporon cutaneum in various environmental conditions. Braz. J. Microbiol. 2024, 55, 1793–1800. [Google Scholar] [CrossRef]
- Duarte-Oliveira, C.; Rodrigues, F.; Gonçalves, S.M.; Goldman, G.H.; Carvalho, A.; Cunha, C. The Cell Biology of the Trichosporon-Host Interaction. Front. Cell. Infect. Microbiol. 2017, 7, 118. [Google Scholar] [CrossRef]
- Bentubo, H.D.L.; Gompertz, O.F. Effects of temperature and incubation time on the in vitro expression of proteases, phospholipases, lipases and DNases by different species of Trichosporon. SpringerPlus 2014, 3, 377. [Google Scholar] [CrossRef]
- Mehta, V.; Nayyar, C.; Gulati, N.; Singla, N.; Rai, S.; Chandar, J. A Comprehensive Review of Trichosporon spp.: An Invasive and Emerging Fungus. Cureus 2021, 13, e17345. [Google Scholar] [CrossRef]
- Pamidimukkala, U.; Sudhaharan, S.; Sundarapu, N.A.R.; Chavali, P. P254 Clinical and microbiological spectrum of invasive trichosporonosis from a tertiary care institute in India. Med. Mycol. 2022, 60 (Suppl. 1), myac072P254. [Google Scholar] [CrossRef]
- Mehta, V.; Chander, J.; Gulati, N.; Singla, N.; Vasdeva, H.; Sardana, R.; Pandey, A.K. Epidemiological profile and antifungal susceptibility pattern of Trichosporon species in a tertiary care hospital in Chandigarh, India. Curr. Med. Mycol. 2021, 7, 19–24. [Google Scholar] [CrossRef]
- Li, H.; Guo, M.; Wang, C.; Li, Y.; Fernandez, A.M.; Ferraro, T.N.; Yang, R.; Chen, Y. Epidemiological study of Trichosporon asahii infections over the past 23 years. Epidemiol. Infect. 2020, 148, e169. [Google Scholar] [CrossRef]
- Urs, T.A.; Kadiyala, V.; Deepak, S.; Karthik, M.K. Catheter associated urinary tract infections due to Trichosporon asahii. J. Lab. Physicians 2018, 10, 464–470. [Google Scholar] [CrossRef]
- Chen, S.C.-A.; Perfect, J.; Colombo, A.L.; Cornely, O.A.; Groll, A.H.; Seidel, D.; Albus, K.; de Almedia, J.N.; Garcia-Effron, G.; Gilroy, N.; et al. Global guideline for the diagnosis and management of rare yeast infections: An initiative of the ECMM in cooperation with ISHAM and ASM. Lancet Infect. Dis. 2021, 21, e375–e386. [Google Scholar] [CrossRef]
- de Almeida, J.N.; Francisco, E.C.; Ruiz, A.H.; Cuéllar, L.E.; Aquino, V.R.; Mendes, A.V.; Queiroz-Telles, F.; Santos, D.W.; Guimarães, T.; Chaves, G.M.; et al. Epidemiology, clinical aspects, outcomes and prognostic factors associated with Trichosporon fungaemia: Results of an international multicentre study carried out at 23 medical centres. J. Antimicrob. Chemother. 2021, 76, 1907–1915. [Google Scholar] [CrossRef]
- Ramírez, I.; Moncada, D. Fatal Disseminated Infection by Trichosporon asahii Under Voriconazole Therapy in a Patient with Acute Myeloid Leukemia: A Review of Breakthrough Infections by Trichosporon spp. Mycopathologia 2019, 185, 377–388. [Google Scholar] [CrossRef]
- de Almeida, J.N.; Moreno, L.; Francisco, E.C.; Marques, G.N.; Mendes, A.V.; Barberino, M.G.; Colombo, A.L. Trichosporon asahii superinfections in critically ill COVID-19 patients overexposed to antimicrobials and corticosteroids. Mycoses 2021, 64, 817–822. [Google Scholar] [CrossRef]
- Lass-Flörl, C.; Kanj, S.S.; Govender, N.P.; Thompson, G.R.; Zeichner, L.O.; Govrins, M.A. Invasive candidiasis. Nat. Rev. Dis. Primers 2024, 10, 20. [Google Scholar] [CrossRef]
- Munshi, A.; Almadani, F.; Ossenkopp, J.; Alharbi, M.; Althaqafi, A.; Alsaedi, A.; Al-Amri, A.; Almarhabi, H. Risk factors, antifungal susceptibility, complications, and outcome of Candida auris bloodstream infection in a tertiary care center in the western region of Saudi Arabia. J. Infect. Public Health 2024, 17, 182–188. [Google Scholar] [CrossRef] [PubMed]
- CDC. Guidelines and Guidance Library. Available online: https://www.cdc.gov/infection-control/hcp/guidance/index.html (accessed on 20 March 2025).
- Kilpatrick, C.; Tartari, E.; Deeves, M.; Pittet, D.; Allegranzi, B. Organização Mundial da Saúde Dia Mundial da Higiene das Mãos, 5 de maio de 2024. SALVE VIDAS: Campanha Limpe suas mãos: Promovendo conhecimento e capacitação sobre prevenção e controle de infecções, incluindo higiene das mãos, entre profissionais de saúde e assistência. Infect. Control Hosp. Epidemiol. 2024, 45, 553. [Google Scholar] [CrossRef]
- Agência Nacional de Vigilância Sanitária. Agência Nacional de Vigilância Sanitária Segurança do Paciente em Serviços de Saúde: Limpeza e Desinfecção de Superfícies; Agência Nacional de Vigilância Sanitária–Anvisa: Brasília, Brazil, 2010. [Google Scholar]
- Fernandes, Â.R.; Rodrigues, A.G.; Cobrado, L. Effect of prolonged exposure to disinfectants in the antimicrobial resistance profile of relevant micro-organisms: A systematic review. J. Hosp. Infect. 2024, 151, 45–59. [Google Scholar] [CrossRef]
- Mirghani, R.; Saba, T.; Khaliq, H.; Mitchell, J.; Do, L.; Chambi, L.; Diaz, K.; Kennedy, T.; Alkassab, K.; Huynh, T.; et al. Biofilms: Formation, drug resistance and alternatives to conventional approaches. AIMS Microbiol. 2022, 8, 239–277. [Google Scholar] [CrossRef]
- Jones, I.A.; Joshi, L.T. Biocide Use in the Antimicrobial Era: A Review. Molecules 2021, 26, 2276. [Google Scholar] [CrossRef]
- Diogo, H.C.; Sarpieri, A.; Pires, M.C. Preservação de fungos em água destilada. An. Bras. Dermatol. 2005, 80, 591–594. [Google Scholar] [CrossRef]
- CLSI. Method for Antifungal Disk Diffusion Susceptibility Testing of Yeasts, 3rd ed.; CLSI supplement M44; Clinical and Laboratory Standards Institute: Berwyn, PA, USA, 2018. [Google Scholar]
- Martins, M.; Viveiros, M.; Couto, I.; Costa, S.S.; Pacheco, T.; Fanning, S.; Pagès, J.-M.; Amaral, L. Identification of efflux pump-mediated multidrug-resistant bacteria by the ethidium bromide-agar cartwheel method. In Vivo 2011, 25, 171–178. [Google Scholar]
- Pramodhini, S.; Srirangaraj, S.; Easow, J.M. Candiduria-Study of Virulence Factors and Its Antifungal Susceptibility Pattern in Tertiary Care Hospital. J. Lab. Physicians 2021, 13, 231–237. [Google Scholar] [CrossRef]
- Alboloshi, G.J.; Jiman-Fatani, A.; Attallah, D.; Mokhtar, J.; Al-Abdullah, N.A.; Alkuwaity, K.; Kaki, R.; Al-Rabia, M.W.; Alfadil, A.; Ibrahem, K.; et al. The Prevalence and Risk Factors of Trichosporonosis at King Abdulaziz University Hospital. Int. J. Gen. Med. 2024, 17, 1297–1310. [Google Scholar] [CrossRef]
- Luis, B.A.L.; León-Palacios, K.A.; Acosta-Ruiz, A.; Gonzalez-Cardel, A.M.; Rodriguez-Zuñiga, G. Clinical significance of nosocomial Trichosporon asahii in urine: A retrospective cohort study. Infect. Dis. Now 2025, 55, 105059. [Google Scholar] [CrossRef]
- Egger, M.; Hoenigl, M.; Thompson, G.R., III; Carvalho, A.; Jenks, J.D. Let’s talk about sex characteristics-As a risk factor for invasive fungal diseases. Mycoses 2022, 65, 599–612. [Google Scholar] [CrossRef] [PubMed]
- Gil, Ó.; Hernández-Pabón, J.C.; Tabares, B.; Lugo-Sánchez, C.; Firacative, C. Rare Yeasts in Latin America: Uncommon Yet Meaningful. J. Fungi 2023, 9, 747. [Google Scholar] [CrossRef]
- Lomas, L.T.; González, M.D.-G.; Luengo, A.I.M.; Bouza, J.M.E.; Pérez, J.M.P. Infección nosocomial por Trichosporon asahii en un paciente quemado crítico [Nosocomial infection due to Trichosporon asahii in a critical burned patient]. Rev. Iberoam. Micol. 2015, 32, 257–260. (In Spanish) [Google Scholar] [CrossRef]
- Giraldi, G.; Montesano, M.; Napoli, C.; Frati, P.; La Russa, R.; Santurro, A.; Scopetti, M.; Orsi, G.B. Healthcare-Associated Infections due to Multidrug-Resistant Organisms: A Surveillance Study on Extra Hospital Stay and Direct Costs. Curr. Pharm. Biotechnol. 2019, 20, 643–652. [Google Scholar] [CrossRef]
- European Commission. Biocides. Available online: https://health.ec.europa.eu/biocides_en (accessed on 12 December 2024).
- Erganis, S.; Ozturk, A.; Uzuntas, S.T.; Kirca, F.; Dogan, A.; Dinc, B.; Kalkanci, A. Variable sensitivity of clinical Candida auris strains to Biocides: Implications for infection control in Healthcare Settings. BMC Microbiol. 2024, 24, 447. [Google Scholar] [CrossRef]
- De Paiva Macedo, J.; Watanabe, A.A.S.; Machado, A.B.F.; Diniz, C.G.; Da Silva, V.L.; Dias, V.C. Unveiling antifungal resistance and biocide tolerance in clinical isolates of Candida spp. Future Microbiol. Future Microbiol. 2025, 20, 457–468. [Google Scholar] [CrossRef]
- Dias, V.C.; Resende, J.A.; Bastos, A.N.; Bastos, L.Q.D.A.; Bastos, V.Q.D.A.; Bastos, R.V.; Diniz, C.G.; Da Silva, V.L. Epidemiological, Physiological, and Molecular Characteristics of a Brazilian Collection of Carbapenem-Resistant Acinetobacter baumannii and Pseudomonas aeruginosa. Microb. Drug Resist. 2017, 23, 852–863. [Google Scholar] [CrossRef]
- Narayanan, V.; Motlekar, S.; Kadhe, G.; Bhagat, S. Efficacy and safety of nadifloxacin for bacterial skin infections: Results from clinical and post-marketing studies. Dermatol. Ther. 2014, 4, 233–248. [Google Scholar] [CrossRef]
- Ma, X.; Yang, W.; Yang, A.; Chen, D.; Wang, C.; Ling, S.; Cao, S.; Zuo, Z.; Wang, Y.; Zhong, Z.; et al. Metabolome and Transcriptome Combinatory Profiling Reveals Fluconazole Resistance Mechanisms of Trichosporon asahii and the Role of Farnesol in Fluconazole Tolerance. Microorganisms 2023, 11, 2798. [Google Scholar] [CrossRef] [PubMed]
- Paiva Macedo, J.; Dias, V.C. Antifungal resistance: Why are we losing this battle? Future Microbiol. 2024, 19, 1027–1040. [Google Scholar] [CrossRef] [PubMed]
- Kurakado, S.; Miyashita, T.; Chiba, R.; Sato, C.; Matsumoto, Y.; Sugita, T. Role of arthroconidia in biofilm formation by Trichosporon asahii. Mycoses 2021, 64, 42–47. [Google Scholar] [CrossRef] [PubMed]
- Lara, B.R.; de Camargo, B.B.; Paula, C.R.; Monari, G.P.d.M.; Garces, H.G.; Arnoni, M.V.; Silveira, M.; Gimenes, V.M.F.; Junior, D.P.L.; Bonfietti, L.X.; et al. Aspects related to biofilm production and antifungal susceptibility of clinically relevant yeasts of the genus Trichosporon. Med. Mycol. 2023, 61, myad022. [Google Scholar] [CrossRef]

| Clinical and Epidemiological Parameters | Trichosporon asahii (n = 37) | |
|---|---|---|
| Gender: n (%) | ||
| Female | 8 (22.6) | |
| Male | 29 (78.4) | |
| Age: n (%) | ||
| ≤12 years | 3 (8.1) | |
| 13–59 years | 12 (32.4) | |
| ≥60 years | 22 (59.5) | |
| Length (in days) of hospitalization: average (range) | 35 (1–102) | |
| Collection unit: n (%) | ||
| Surgical center | 5 (13.5) | |
| Non-hospitalized | 6 (16.2) | |
| Coronary unit | 1 (2.7) | |
| Inpatient unit | 9 (24.3) | |
| General ICU | 3 (8.1) | |
| Neurological ICU | 11 (29.7) | |
| Neonatal ICU | 2 (5.4) | |
| Clinical specimen: n (%) | ||
| Bronchoalveolar lavage | 10 (27.1) | |
| Nail scraping | 1 (2.7) | |
| Scalp hair | 1 (2.7) | |
| Skin shave | 2 (5.4) | |
| Tracheal aspirate | 2 (5.4) | |
| Urine | 21 (56.7) | |
| Clinical outcome: n = 31 | ||
| Hospital discharge | 15 (48.4) | |
| Death | 16 (51.6) | |
| Biocide | Average Inhibition Halo Diameter (mm) | Test-t Student | Test-F p (F ≤ f) | |
|---|---|---|---|---|
| Trichosporon asahii (n = 37) | T. asahii ATCC 90039 (n = 2) | |||
| Sodium hypochlorite 1% | 11.4 (±4.34) | 16.0 (±5.66) | 0.45 | 0.40 |
| Sodium hypochlorite 1.5% | 13.1 (±5.31) | 18.0 (±4.24) | 0.33 | 0.86 |
| Sodium hypochlorite 2% | 16.4 (±6.01) | 32.5 (±10.61) | 0.27 | 0.17 |
| Ethyl alcohol 70% | 6.1 (±0.09) | 9.0 (±1.42) | 0.21 | 0.00 |
| Hydrogen peroxide 4.25% | 6.1 (±0.09) | 8.5 (±0.71) | 0.13 | 0.00 |
| Benzalkonium chloride 5% | 6.1 (±0.13) | 7.5 (±0.72) | 0.21 | 0.00 |
| Biocide | pH Range | Classification |
|---|---|---|
| Sodium hypochlorite | pH 11–13 | Alkaline |
| Ethyl alcohol | pH neutral to slightly acidic | Neutral/Slightly acidic |
| Hydrogen peroxide | pH 3.5–4.5 | Acidic |
| Benzalkonium chloride | pH 6–8 | Neutral/Slightly alkaline |
| Isolate | Biocide | Test-t Student | Test-F p (F ≤ f) | |
|---|---|---|---|---|
| Trichosporon asahii (n = 37) | Sodium hypochlorite 1% 11.4 (±4.34) | Sodium hypochlorite 1.5% 13.1 (±5.31) | ||
| 0.140954942 | 0.22 | |||
| Sodium hypochlorite 1% 11.4 (±4.34) | Sodium hypochlorite 2% 16.4 (±6.01) | |||
| 0.000060699 * | 0.04 | |||
| Sodium hypochlorite 1% 11.4 (±4.34) | Ethyl alcohol 70% 6.1 (±0.09) | |||
| 0.00000000002 * | 0.00 | |||
| Sodium hypochlorite 1% 11.4 (±4.34) | Hydrogen peroxide 4.25% 6.1 (±0.09) | |||
| 0.000000002 * | 0.00 | |||
| Sodium hypochlorite 1% 11.4 (±4.34) | Benzalkonium chloride 5% 6.1 (±0.13) | |||
| 0.0000000000 * | 0.00 | |||
| Isolate | Etbr Concentration | ||||
|---|---|---|---|---|---|
| 0.5% (n/%) | 1.0% (n/%) | 1.5% (n/%) | 2.0% (n/%) | 2.5% (n/%) | |
| T. asahii (n = 37) | 37.0/100.0 | 34.0/91.9 | 37.0/100.0 | 37.0/100.0 | 37.0/100.0 |
| T. asahii ATCC 90039 (n = 2) | 2.0/100.0 | 2.0/100.0 | 2.0/100.0 | 2.0/100.0 | 2.0/100.0 |
| OR (95% Confidence Interval) | |
|---|---|
| Biofilm formation | Efflux pump expression |
| 0.47 | 2.13 |
| (0.11–2.11) | (0.17–26.04) |
| Virulence Factor | Non-Hospitalized Individuals (n = 06/16.2%) | Discharged Individuals (n = 15/40.5%) | Individuals with Hospital Death (n = 16/43.3%) |
|---|---|---|---|
| Biofilm formation | n = 3/8.1 | n = 11/29.7 | n = 10/27.1 |
| Efflux pump expression | n = 6/16.2 | n = 13/35.2 | n = 15/40.5 |
| Tolerance to biocides | n = 4/10.8 (3 biocides) | n = 12/32.4 (3 biocides) | n = 14/37.8 (3 biocides) |
| n = 1/2.7 (*4 biocides) | n = 3/8.1 (*4 biocides) | n = 2/5.4 (*4 biocides) | |
| *Two concentration* | *One concentration* | *All concentrations* | |
| Biofilm formation + efflux pump expression + Tolerance to biocides | n = 2/5.4 (3 biocides) | n = 6/16.2 (3 biocides) | n = 9/24.3 (3 biocides) |
| n = 1/2.7 (*4 biocides) | n = 3/8.1 (*4 biocides) | n = 1/2.7 (*4 biocides) | |
| *Two concentrations* | *One concentration* | *All concentrations* |
Disclaimer/Publisher’s Note: The statements, opinions and data contained in all publications are solely those of the individual author(s) and contributor(s) and not of MDPI and/or the editor(s). MDPI and/or the editor(s) disclaim responsibility for any injury to people or property resulting from any ideas, methods, instructions or products referred to in the content. |
© 2025 by the authors. Licensee MDPI, Basel, Switzerland. This article is an open access article distributed under the terms and conditions of the Creative Commons Attribution (CC BY) license (https://creativecommons.org/licenses/by/4.0/).
Share and Cite
Passos Lima, Y.; de Paiva Macedo, J.; Barbosa Ferreira Machado, A.; Galuppo Diniz, C.; da Silva, V.L.; Cordeiro Dias, V. Biocide Tolerance, Biofilm Formation, and Efflux Pump Activity in Clinical Isolates of Trichosporon asahii. Infect. Dis. Rep. 2025, 17, 97. https://doi.org/10.3390/idr17040097
Passos Lima Y, de Paiva Macedo J, Barbosa Ferreira Machado A, Galuppo Diniz C, da Silva VL, Cordeiro Dias V. Biocide Tolerance, Biofilm Formation, and Efflux Pump Activity in Clinical Isolates of Trichosporon asahii. Infectious Disease Reports. 2025; 17(4):97. https://doi.org/10.3390/idr17040097
Chicago/Turabian StylePassos Lima, Yasmim, Jamile de Paiva Macedo, Alessandra Barbosa Ferreira Machado, Cláudio Galuppo Diniz, Vania Lucia da Silva, and Vanessa Cordeiro Dias. 2025. "Biocide Tolerance, Biofilm Formation, and Efflux Pump Activity in Clinical Isolates of Trichosporon asahii" Infectious Disease Reports 17, no. 4: 97. https://doi.org/10.3390/idr17040097
APA StylePassos Lima, Y., de Paiva Macedo, J., Barbosa Ferreira Machado, A., Galuppo Diniz, C., da Silva, V. L., & Cordeiro Dias, V. (2025). Biocide Tolerance, Biofilm Formation, and Efflux Pump Activity in Clinical Isolates of Trichosporon asahii. Infectious Disease Reports, 17(4), 97. https://doi.org/10.3390/idr17040097

